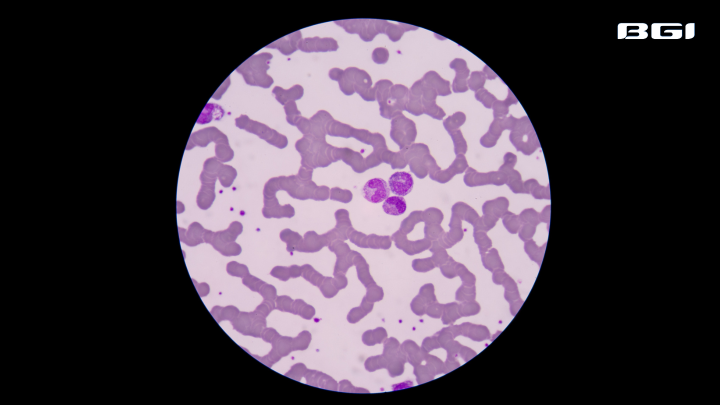

One Life Lost to Sepsis Every Three Seconds | World Sepsis Day
2025-09-12
Every three seconds, one life is lost to sepsis, according to the Global Sepsis Alliance. It is a life-threatening, dysregulated immune response to infection and remains a leading cause of death worldwide. Most of these deaths are preventable with timely intervention.
Conventional culturing diagnostic methods are often slow and imprecise. The advancement of metagenomic and targeted next-generation sequencing (mNGS and tNGS) now provides rapid precision diagnostics, enabling earlier treatment.
The global health community observes World Sepsis Day on September 13 to raise awareness of this medical emergency and the urgent need for better prevention, diagnosis, and treatment strategies.
Global Burden of Sepsis
Sepsis accounts for an estimated 50 million cases and 11 million deaths annually, equivalent to one life lost every three seconds. Data from the Global Sepsis Alliance and the World Health Organization (WHO) reveal the disproportionate impact on vulnerable populations.
Nearly half of all cases occur in children under five years of age. Thirty-day mortality in septic shock averages 34.7%, according to a study published in BMC Critical Care.
The pathophysiology of sepsis involves an overwhelming immune response that disrupts vascular integrity, lowers systemic blood pressure, and induces multi-organ dysfunction. While the initial presentation may resemble a minor infection, progression to life-threatening illness can occur within hours.
Diagnosis Remains Difficult
Image: Blood smear of sepsis.
Diagnosis relies on blood cultures and scoring systems such as the quick Sequential Organ Failure Assessment (qSOFA). While qSOFA offers a practical means of risk stratification, blood cultures are time-consuming and often inconclusive, especially in patients already treated with anti-microbial.
Not all sepsis-like syndromes are caused by pathogens. Severe pancreatitis, major trauma, burns, or autoimmune disease can trigger systemic inflammatory response syndrome (SIRS), closely mimicking infection. This diagnostic overlap complicates treatment, increases unnecessary antibiotic use, and contributes to the rise of multidrug-resistant organisms. These diagnostic gaps underline the need for faster, more precise methods.
Precision Save Life: Patient’s Voice
For a 13-year-old girl, Cathy, undergoing chemotherapy for B-cell acute lymphoblastic leukemia, infection quickly became life-threatening. Chemotherapy had left her immune system severely weakened. When she developed five days of high fever, cough, and low oxygen levels, doctors treated her with strong intravenous antibiotics.
Yet her condition worsened—breathing grew difficult, blood pressure dropped, and her organs began to fail. Even antifungal therapy did not stop the decline. She was admitted to the pediatric intensive care unit with sepsis, and time was running out.
Her clinicians turned to high-throughput sequencing for answers. A blood test using BGI Genomics' PMseq™ detected Candida tropicalis and cytomegalovirus (CMV). At the same time, targeted sequencing (PTseq™ plus) of lung fluid confirmed a high level of Candida tropicalis.
With these rapid, precise results, her treatment was adjusted to liposomal amphotericin B for the fungal infection and ganciclovir for CMV. Within a week, her fever subsided, oxygen levels improved, and she was stable enough to leave intensive care.
Advanced Sequencing Supports Diagnosis
Advances in high-throughput sequencing (HTS) technologies, including mNGS and tNG, have expanded diagnostic capabilities beyond culture-dependent methods and helped patients like the 13-year-old Cathy around the world.
The mNGS provides an unbiased approach by analyzing all nucleic acids in a clinical specimen. This method can detect bacteria, fungi, viruses, and parasites simultaneously, regardless of prior antimicrobial exposure. Tools such as BGI Genomics’ PMseq™ (Pathogen Metagenomic Sequencing) compare sequence reads against reference libraries covering more than 36,000 microbial species, uncovering atypical, rare, or polymicrobial infections.
The tNGS panels complement metagenomic approaches by focusing on high-value pathogens and resistance determinants. BGI Genomics’ PTseq™ plus, for example, interrogates 729 clinically relevant pathogens and 130 resistance and virulence genes. It can deliver results within 15 hours. The panel covers respiratory, bloodstream, central nervous system, and abdominal infections, representing more than 98% of common clinical scenarios.
The value of HTS lies in its ability to provide actionable results within the first 24 hours. Negative findings redirect attention toward non-infectious causes, reducing inappropriate antibiotic use. Moreover, integrating HTS into sepsis management can reduce healthcare costs by shortening ICU stays and limiting complications from unnecessary broad-spectrum antibiotics.
Sepsis remains a major global health challenge due to its rapid onset, high mortality, and diagnostic complexity. On World Sepsis Day, we advocate for awareness, innovation, and precision medicine to turn knowledge into action and reduce the global burden of sepsis.
For privacy reasons, we have decided not to reveal the child's real name and use a fictitious name instead.
About BGI Genomics PMseq™ Pathogen Metagenomics Sequencing
PMseq™ applies metagenomic next-generation sequencing (mNGS) to nucleic acids extracted from clinical infection samples. It enables unbiased detection of bacteria, fungi, viruses, parasites, and other pathogens, while also identifying drug resistance and virulence genes. By delivering rapid and accurate results, PMseq™ supports precise diagnosis and guides targeted antibiotic use.
About BGI Genomics Pan-infection Pathogen Targeted Sequencing (PTseq™ plus)
PTseq™ plus uses targeted next-generation sequencing (tNGS) with specialized hybridization probes to enrich and sequence pathogenic genes. Leveraging a high-quality clinical database, patented technologies, and advanced bioinformatics, it identifies pathogens, resistance markers, and virulence genes with speed and accuracy. PTseq™ Plus provides clinicians with actionable insights for precise infection diagnosis and treatment.
About BGI Genomics
BGI Genomics, headquartered in Shenzhen, China, is the world's leading integrated solutions provider of precision medicine. Our services cover more than 100 countries and regions, involving more than 2,300 medical institutions. In July 2017, as a subsidiary of BGI Group, BGI Genomics (300676.SZ) was officially listed on the Shenzhen Stock Exchange.